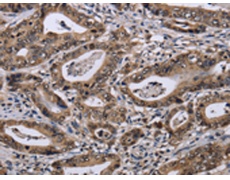
一抗

|
Background: |
The protein encoded by this gene is a member of the dual specificity protein phosphatase subfamily. These phosphatases inactivate their target kinases by dephosphorylating both the phosphoserine/threonine and phosphotyrosine residues. They negatively regulate members of the mitogen-activated protein (MAP) kinase superfamily (MAPK/ERK, SAPK/JNK, p38), which are associated with cellular proliferation and differentiation. Different members of the family of dual specificity phosphatases show distinct substrate specificities for various MAP kinases, different tissue distribution and subcellular localization, and different modes of inducibility of their expression by extracellular stimuli. |
|
Applications: |
ELISA, WB, IHC |
|
Name of antibody: |
DUSP4 |
|
Immunogen: |
Fusion protein of human DUSP4 |
|
Full name: |
dual specificity phosphatase 4 |
|
Synonyms: |
TYP; HVH2; MKP2; MKP-2 |
|
SwissProt: |
Q13115 |
|
IHC positive control: |
Human gastric cancer and human liver cancer |
|
IHC Recommend dilution: |
50-200 |
|
WB Predicted band size: |
43 kDa |
|
WB Positive control: |
LO2 cells |
|
WB Recommended dilution: |
200-1000 |


 購物車
購物車 幫助
幫助
 021-54845833/15800441009
021-54845833/15800441009